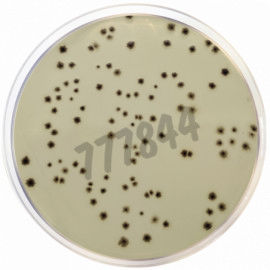
Milieu déshydraté gelose au sulfite de fer 500 g

Milieux de bactériologie et additifs
4723 produits - Trié par pertinence
Cca coliforms, agar chromogène , boîte précoulée (diamètre 55 mm) pour la microbiologie 30 boîtes
Réf. UGAP : 3665886 Réf. constructeur : 446910.0922
CELL DISSOC.BUF/ENZ.FREE HANKS produits de dissociation de cellules 100 mL
Réf. UGAP : 3772957 Réf. constructeur : 13150016